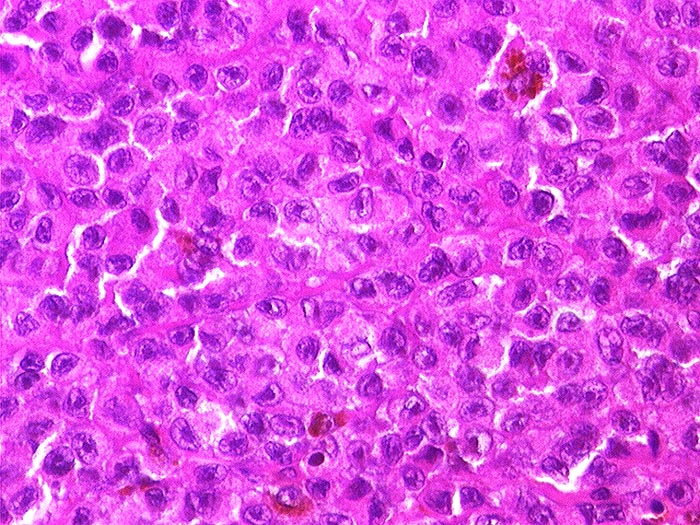

PathoPic – image database / PathoPic ID 1080 - Malignes Melanom
de
Diagnose
Malignes Melanom
Diagnose Gruppe
maligner Tumor
Topographie
Haut, Rumpf
Topographie Gruppe
Haut
Beschreibung
Synzytiale Tumormasse mit einzelnen pigmentierten Zellen. Grosse Kerne mit prominenten eosinophilen Nukleolen. Reichlich eosinophiles Zytoplasma.
Klinik
Metastase eines nodulären malignen Melanoms der Schulterhaut.
Bilder Typ
Histologie
Alter
81
Geschlecht
männlich
Datum
Ersteintrag: 28.11.2001
Update: 04.02.2024